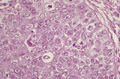

- 6.Mediastinum
- (2)Thymic carcinoma
Macroscopic view: Macroscopically, tumor has a lobulated appearance as in thymoma. The tumor circumference is irregular (dotted line), indicating invasion into the surrounding tissue.
Click the image to see the enlarged image.